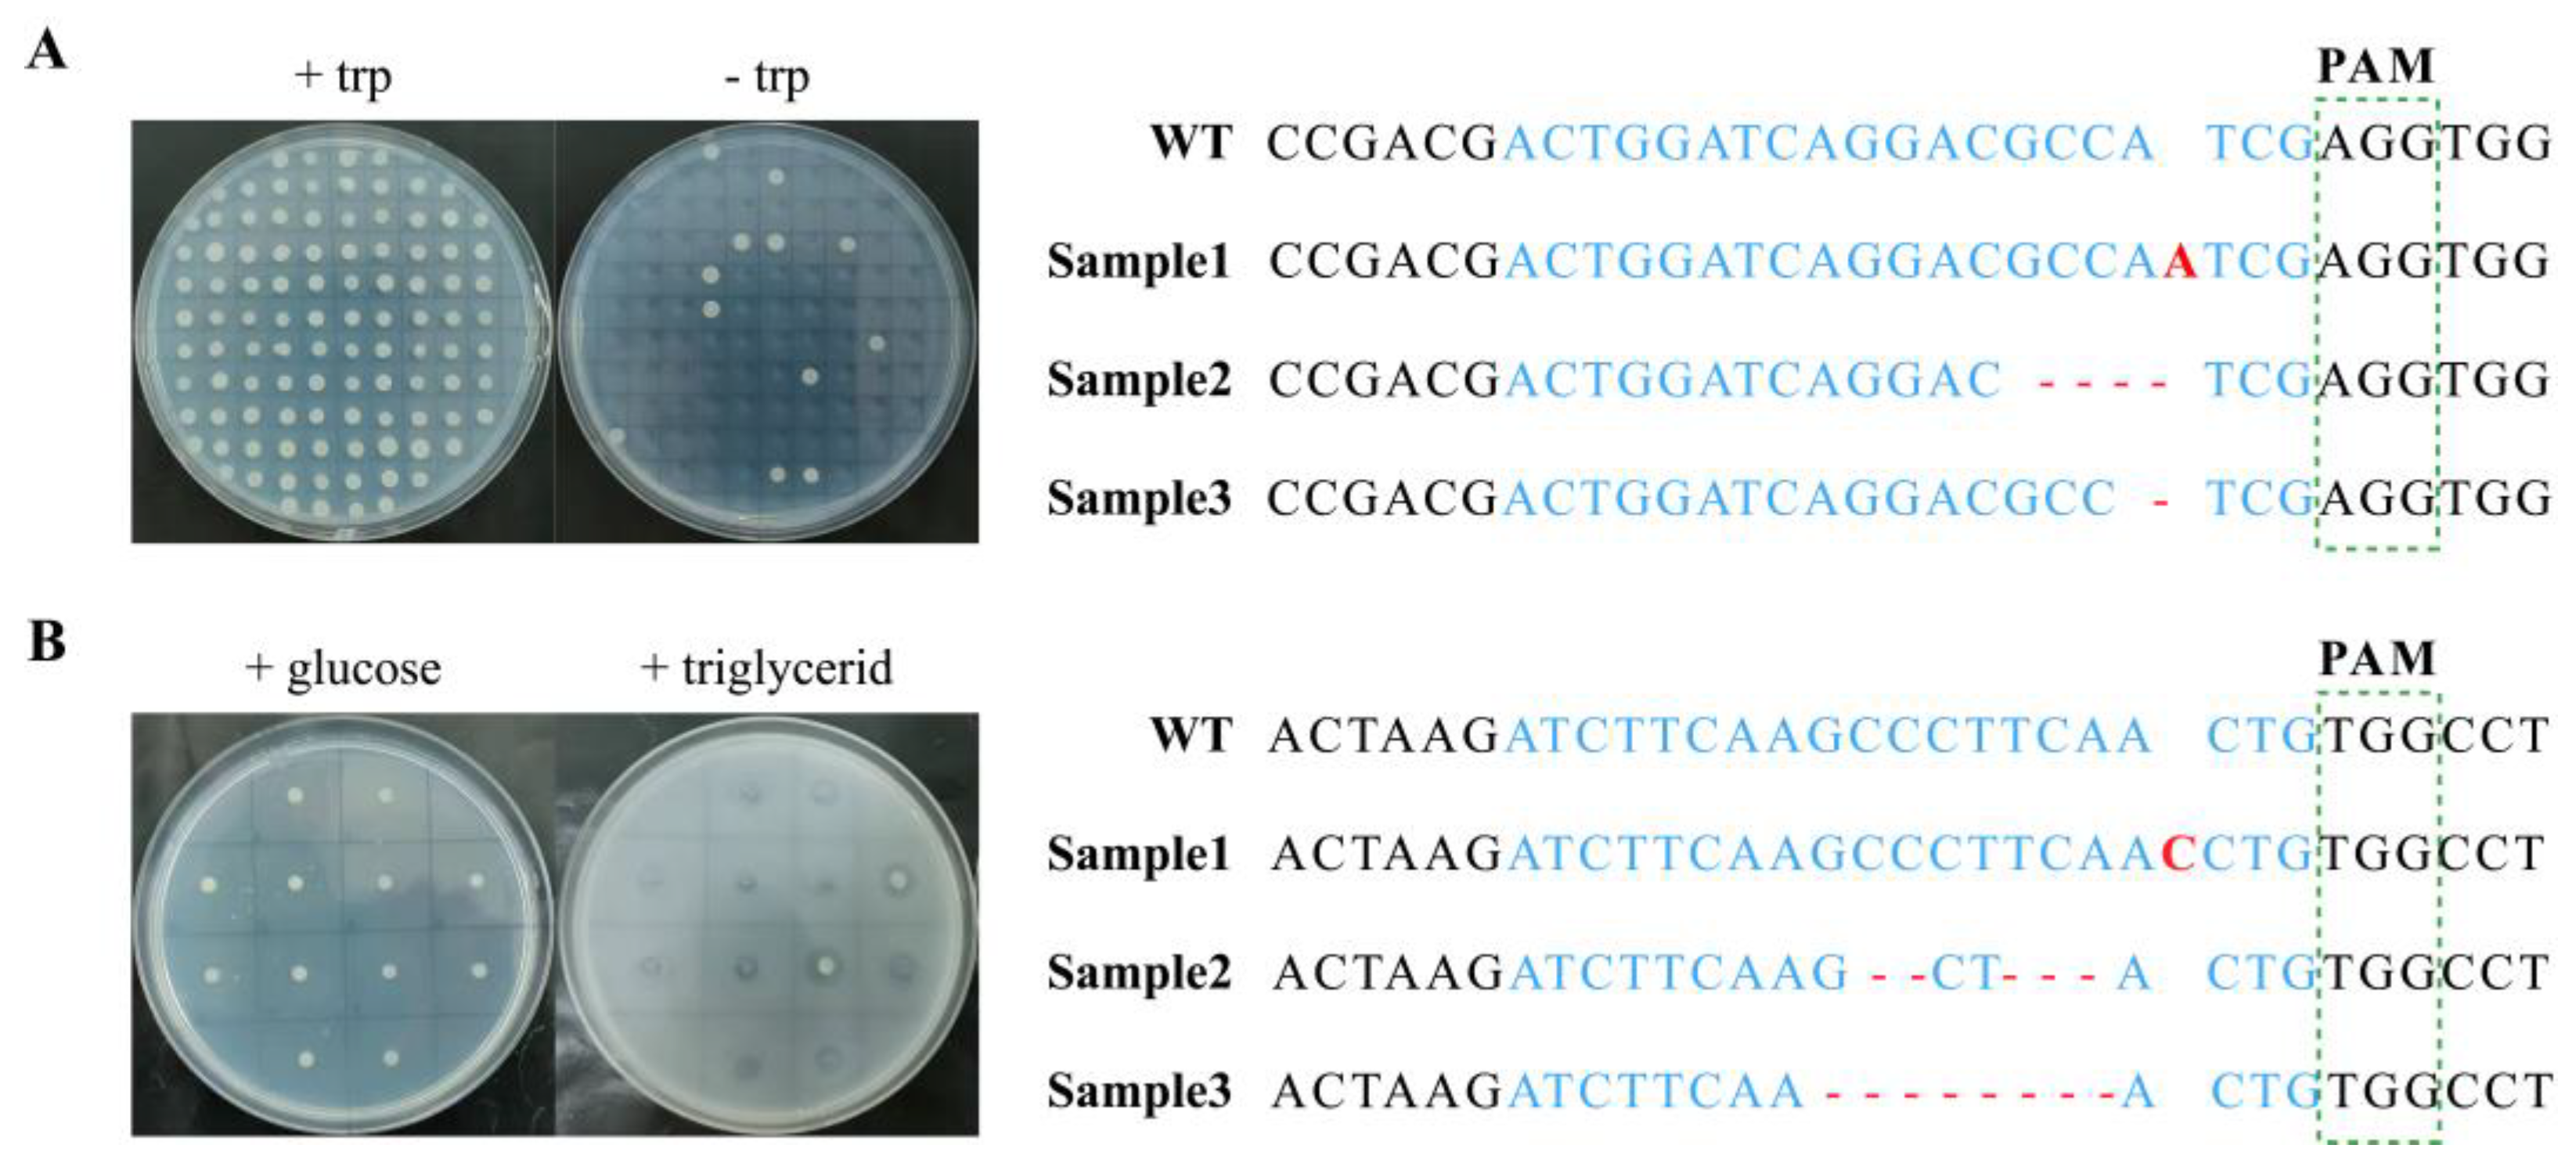
Jof 10 00063 g001

Improving and Streamlining Gene Editing in Yarrowia lipolytica via Integration of Engineered Cas9 Protein
Abstract
1. Introduction
2. Materials and Methods
2.1. Strains, Media, and Culture Conditions
2.2. Plasmid Construction
2.3. Yeast Transformation
2.4. Phenotype Verification
2.5. Colony PCR Confirmation and Sequencing
2.6. Real-Time Quantitative PCR
3. Results and Discussion
3.1. Gene Editing Efficiency of eSpCas9 in Y. lipolytica
3.2. Integration of eSpCas9 in Y. lipolytica
3.3. Effect of Enhancing Gene Expression Level of Integrated eSpCas9 on Gene Editing Efficiency
3.4. Effect of Integrated eSpCas9 on Growth of Y. lipolytica
4. Conclusions
Supplementary Materials
Author Contributions
Funding
Institutional Review Board Statement
Informed Consent Statement
Data Availability Statement
Acknowledgments
Conflicts of Interest
References
- Raschmanova, H.; Weninger, A.; Glieder, A.; Kovar, K.; Vogl, T. Implementing CRISPR-Cas technologies in conventional and non-conventional yeasts: Current state and future prospects. Biotechnol. Adv. 2018, 36, 641–665. [Google Scholar] [CrossRef]
- Naseri, G.; Koffas, M.A.G. Application of combinatorial optimization strategies in synthetic biology. Nat. Commun. 2020, 11, 2446. [Google Scholar] [CrossRef] [PubMed]
- Brooks, S.M.; Alper, H.S. Applications, challenges, and needs for employing synthetic biology beyond the lab. Nat. Commun. 2021, 12, 1390. [Google Scholar] [CrossRef] [PubMed]
- Madzak, C. Yarrowia lipolytica strains and their biotechnological applications: How natural biodiversity and metabolic engineering could contribute to cell factories improvement. J. Fungi 2021, 7, 548. [Google Scholar] [CrossRef]
- Miller, K.K.; Alper, H.S. Yarrowia lipolytica: More than an oleaginous workhorse. Appl. Microbiol. Biotechnol. 2019, 103, 9251–9262. [Google Scholar] [CrossRef] [PubMed]
- Fickers, P.; Cheng, H.; Sze Ki Lin, C. Sugar alcohols and organic acids synthesis in Yarrowia lipolytica: Where are we? Microorganisms 2020, 8, 574. [Google Scholar] [CrossRef] [PubMed]
- Egermeier, M.; Russmayer, H.; Sauer, M.; Marx, H. Metabolic flexibility of Yarrowia lipolytica growing on glycerol. Front. Microbiol. 2017, 8, 49. [Google Scholar] [CrossRef] [PubMed]
- Xue, Z.; Sharpe, P.L.; Hong, S.P.; Yadav, N.S.; Xie, D.; Short, D.R.; Damude, H.G.; Rupert, R.A.; Seip, J.E.; Wang, J.; et al. Production of omega-3 eicosapentaenoic acid by metabolic engineering of Yarrowia lipolytica. Nat. Biotechnol. 2013, 31, 734–740. [Google Scholar] [CrossRef]
- Zhang, B.; Chen, H.; Li, M.; Gu, Z.; Song, Y.; Ratledge, C.; Chen, Y.Q.; Zhang, H.; Chen, W. Genetic engineering of Yarrowia lipolytica for enhanced production of trans-10, cis-12 conjugated linoleic acid. Microb. Cell Factories 2013, 12, 70. [Google Scholar] [CrossRef]
- Obsen, T.; Faergeman, N.J.; Chung, S.; Martinez, K.; Gobern, S.; Loreau, O.; Wabitsch, M.; Mandrup, S.; McIntosh, M. Trans-10, cis-12 conjugated linoleic acid decreases de novo lipid synthesis in human adipocytes. J. Nutr. Biochem. 2012, 23, 580–590. [Google Scholar] [CrossRef]
- Liu, Y.; Jiang, X.; Cui, Z.; Wang, Z.; Qi, Q.; Hou, J. Engineering the oleaginous yeast Yarrowia lipolytica for production of alpha-farnesene. Biotechnol. Biofuels 2019, 12, 296. [Google Scholar] [CrossRef] [PubMed]
- Wei, W.; Zhang, P.; Shang, Y.; Zhou, Y.; Ye, B.C. Metabolically engineering of Yarrowia lipolytica for the biosynthesis of naringenin from a mixture of glucose and xylose. Bioresour. Technol. 2020, 314, 123726. [Google Scholar] [CrossRef] [PubMed]
- Park, Y.K.; Ledesma-Amaro, R. What makes Yarrowia lipolytica well suited for industry? Trends Biotechnol. 2023, 41, 242–254. [Google Scholar] [CrossRef] [PubMed]
- Mir, A.; Edraki, A.; Lee, J.; Sontheimer, E.J. Type II-C CRISPR-Cas9 biology, mechanism, and application. ACS Chem. Biol. 2018, 13, 357–365. [Google Scholar] [CrossRef] [PubMed]
- Ran, F.A.; Hsu, P.D.; Wright, J.; Agarwala, V.; Scott, D.A.; Zhang, F. Genome engineering using the CRISPR-Cas9 system. Nat. Protoc. 2013, 8, 2281–2308. [Google Scholar] [CrossRef] [PubMed]
- Asmamaw, M.; Zawdie, B. Mechanism and applications of CRISPR/Cas-9-mediated genome editing. Biologics 2021, 15, 353–361. [Google Scholar] [CrossRef]
- Shi, T.Q.; Huang, H.; Kerkhoven, E.J.; Ji, X.J. Advancing metabolic engineering of Yarrowia lipolytica using the CRISPR/Cas system. Appl. Microbiol. Biotechnol. 2018, 102, 9541–9548. [Google Scholar] [CrossRef]
- Schwartz, C.M.; Hussain, M.S.; Blenner, M.; Wheeldon, I. Synthetic RNA polymerase III promoters facilitate high-efficiency CRISPR-Cas9-mediated genome editing in Yarrowia lipolytica. ACS Synth. Biol. 2016, 5, 356–359. [Google Scholar] [CrossRef]
- Gao, S.; Tong, Y.; Wen, Z.; Zhu, L.; Ge, M.; Chen, D.; Jiang, Y.; Yang, S. Multiplex gene editing of the Yarrowia lipolytica genome using the CRISPR-Cas9 system. J. Ind. Microbiol. Biotechnol. 2016, 43, 1085–1093. [Google Scholar] [CrossRef]
- Sander, J.D.; Joung, J.K. CRISPR-Cas systems for editing, regulating and targeting genomes. Nat. Biotechnol. 2014, 32, 347–355. [Google Scholar] [CrossRef]
- Guo, C.; Ma, X.; Gao, F.; Guo, Y. Off-target effects in CRISPR/Cas9 gene editing. Front. Bioeng. Biotechnol. 2023, 11, 1143157. [Google Scholar] [CrossRef]
- Wilding-Steele, T.; Ramette, Q.; Jacottin, P.; Soucaille, P. Improved CRISPR/Cas9 tools for the rapid metabolic engineering of Clostridium acetobutylicum. Int. J. Mol. Sci. 2021, 22, 3704. [Google Scholar] [CrossRef] [PubMed]
- Slaymaker, I.M.; Gao, L.; Zetsche, B.; Scott, D.A.; Yan, W.X.; Zhang, F. Rationally engineered Cas9 nucleases with improved specificity. Science 2016, 351, 84–88. [Google Scholar] [CrossRef] [PubMed]
- Madzak, C.; Treton, B.; Blanchin-Roland, S. Strong hybrid promoters and integrative expression/secretion vectors for quasi-constitutive expression of heterologous proteins in the yeast Yarrowia lipolytica. J. Mol. Microbiol. Biotechnol. 2000, 2, 207–216. [Google Scholar]
- Nicaud, J.M.; Madzak, C.; van den Broek, P.; Gysler, C.; Duboc, P.; Niederberger, P.; Gaillardin, C. Protein expression and secretion in the yeast Yarrowia lipolytica. FEMS Yeast Res. 2002, 2, 371–379. [Google Scholar] [CrossRef]
- Hsu, P.D.; Scott, D.A.; Weinstein, J.A.; Ran, F.A.; Konermann, S.; Agarwala, V.; Li, Y.; Fine, E.J.; Wu, X.; Shalem, O.; et al. DNA targeting specificity of RNA-guided Cas9 nucleases. Nat. Biotechnol. 2013, 31, 827–832. [Google Scholar] [CrossRef]
- Koonin, E.V.; Gootenberg, J.S.; Abudayyeh, O.O. Discovery of diverse CRISPR-Cas systems and expansion of the genome engineering toolbox. Biochemistry 2023, 62, 3465–3487. [Google Scholar] [CrossRef] [PubMed]
- Gong, G.; Zhang, Y.; Wang, Z.; Liu, L.; Shi, S.; Siewers, V.; Yuan, Q.; Nielsen, J.; Zhang, X.; Liu, Z. GTR 2.0: gRNA-tRNA array and cas9-ng based genome disruption and single-nucleotide conversion in Saccharomyces cerevisiae. ACS Synth. Biol. 2021, 10, 1328–1337. [Google Scholar] [CrossRef] [PubMed]
- Mans, R.; van Rossum, H.M.; Wijsman, M.; Backx, A.; Kuijpers, N.G.; van den Broek, M.; Daran-Lapujade, P.; Pronk, J.T.; van Maris, A.J.; Daran, J.M. CRISPR/Cas9: A molecular Swiss army knife for simultaneous introduction of multiple genetic modifications in Saccharomyces cerevisiae. FEMS Yeast Res. 2015, 15, fov004. [Google Scholar] [CrossRef]
- Pignede, G.; Wang, H.J.; Fudalej, F.; Seman, M.; Gaillardin, C.; Nicaud, J.M. Autocloning and amplification of LIP2 in Yarrowia lipolytica. Appl. Environ. Microbiol. 2000, 66, 3283–3289. [Google Scholar] [CrossRef]
- Duda, K.; Lonowski, L.A.; Kofoed-Nielsen, M.; Ibarra, A.; Delay, C.M.; Kang, Q.; Yang, Z.; Pruett-Miller, S.M.; Bennett, E.P.; Wandall, H.H.; et al. High-efficiency genome editing via 2A-coupled co-expression of fluorescent proteins and zinc finger nucleases or CRISPR/Cas9 nickase pairs. Nucleic Acids Res. 2014, 42, e84. [Google Scholar] [CrossRef] [PubMed]
- Tai, M.; Stephanopoulos, G. Engineering the push and pull of lipid biosynthesis in oleaginous yeast Yarrowia lipolytica for biofuel production. Metab. Eng. 2013, 15, 1–9. [Google Scholar] [CrossRef] [PubMed]
- Blazeck, J.; Liu, L.; Redden, H.; Alper, H. Tuning gene expression in Yarrowia lipolytica by a hybrid promoter approach. Appl. Environ. Microbiol. 2011, 77, 7905–7914. [Google Scholar] [CrossRef] [PubMed]
- Shin, J.; Lee, N.; Song, Y.; Park, J.; Kang, T.J.; Kim, S.C.; Lee, G.M.; Cho, B.K. Efficient CRISPR/Cas9-mediated multiplex genome editing in CHO cells high-level sgRNA-Cas9 complex. Biotechnol. Bioprocess Eng. 2015, 20, 825–833. [Google Scholar] [CrossRef]
- Jacobs, J.Z.; Ciccaglione, K.M.; Tournier, V.; Zaratiegui, M. Implementation of the CRISPR-Cas9 system in fission yeast. Nat. Commun. 2014, 5, 5344. [Google Scholar] [CrossRef] [PubMed]
- Cui, L.; Vigouroux, A.; Rousset, F.; Varet, H.; Khanna, V.; Bikard, D. A CRISPRi screen in E. coli reveals sequence-specific toxicity of dCas9. Nat. Commun. 2018, 9, 1912. [Google Scholar] [CrossRef]

| Strains or Plasmids | Characteristics | Source or References |
|---|---|---|
| Strains | ||
| Po1f | MatA, leu2-270, ura3-302, xpr2-322, axp-2, Leu−, Ura−, ΔAEP, ΔAXP, Suc+ | [24] |
| Po1g | MatA, leu2-270, ura3-302: :URA3, xpr2-322, axp-2, Leu−, ΔAEP, ΔAXP, Suc+, pBR | [24] |
| Po1fe-3 | Po1f, pINA1312-TEFin-eCAS9 (URA3, eSpCas9) | This work |
| Po1fe-4 | Po1f, pINA1312-UAS16TEFin-eCAS9 (URA3, eSpCas9) | This work |
| Po1f-ura+ | Po1f, pINA1312 (URA3) | This work |
| Plasmids | ||
| pCASyl-trp | Y. lipolytica-replicative plasmid, containing TRP1 Guide RNA module and Cas9 expression cassette | [19] |
| pINA1312 | Y. lipolytica-integrative plasmid, Kan, hp4d, XPR2t, ura3d1 | [25] |
| pUC57-UAS1B8 | Containing 8 tandem copies of UAS1B flanked with ClaI-HindIII-SpeI siteson the 5′-end and MluI-XbaI sites on the 3′-end. | [9] |
| pUC57-USA1B16 | Derived from pUC57-UAS1B8, containing 16 tandem copies of UAS1B | This work |
| peCASyl | Derived from pCASyl-trp, replacing Cas9 gene to codon-optimized eSpCas9 gene | This work |
| peCASyl-trp | Derived from peCASyl, containing TRP1 Guide RNA module | This work |
| pINA1312-TEFin-eCAS9 | pINA1312 containing TEFin-eSpCas9 cassette | This work |
| pINA1312-UAS16TEFin-eCAS9 | pINA1312 containing UAS16TEFin-eSpCas9 cassette | This work |
| pCEN1-Leu-gRNA | Derived from pCASyl-trp, containing empty sgRNA cassette | This work |
| pCEN1-Leu-gTRP1 | Derived from pCEN1-Leu-gRNA, containing TRP1 Guide RNA module | This work |
| pCEN1-Leu-gLIP2 | Derived from pCEN1-Leu-gRNA, containing LIP2 Guide RNA module | This work |
| Primers | Sequence (5′-3′) |
|---|---|
| eCAS9-F10 | ACATGGAATTCGGACACGGGccgacgcgtctgtacaga |
| eCAS9-R10 | AGTCTGCAGCCCAAGCTAGCgcccttttgggtttgtcgac |
| pINA1312-F | CCCGTGTCCGAATTCCATGTGTAAC |
| pINA1312-R | GCTAGCTTGGGCTGCAGACTAAATT |
| pINA1312-R-2 | GACACCTCAGCATGCACTAGgctagcttgggctgcagactaaatt |
| Mig1t-F2 | agacatagcggccgcttcgaaaacccaaaagggccgaagg |
| TEF-R2 | ggggttccgcacacatttccagagaccgggttggcgg |
| AmpR-F | ggaaatgtgtgcggaacccc |
| ORI001-R | tcgaagcggccgctatgtct |
| NdeI-F | GTGCGGTATTTCACACCGCAtatggtgcactctcagtacaatctgc |
| NdeI-R | tgcggtgtgaaataccgcac |
| gRNA-Trp-F | CGATGGCGTCCTGATCCAGTgacgagcttactcgtttcg |
| gRNA-Trp-R | ACTGGATCAGGACGCCATCGgttttagagctagaaatagcaagt |
| gRNA-LIP-F | CAGTTGAAGGGCTTGAAGATgacgagcttactcgtttcg |
| gRNA-LIP-R | ATCTTCAAGCCCTTCAACTGgttttagagctagaaatagcaagt |
| eCas9-F | ATCGCCACCGAGCTGACT |
| eCas9-R | GACAAGAAGTACTCAATCGGCCTGG |
| TRP-F | ATGGACTTTCTCTACTCTTCGACAT |
| TRP-R | TTACCCCCTGGCGTTTTTGAC |
| LIP-F | CCCAAGTACCAGCTCCCCTC |
| LIP-R | CCACAGACACCCTCGGTGAC |
| Suc2-F | CTACGGTTCAGCATTAGGTATTG |
| Suc2-R | GACCAGGGACCAGCATTAC |
| ura3-F | GTGCTTCTCTGGATGTTACC |
| ura3-R | CAATATCTGCGAACTTTCTGTC |
| ACT2-F | TCCAGGCCGTCCTCTCCC |
| ACT2-R | GGCCAGCCATATCGAGTCGCA |
| qeCAS9-F2 | TAAGCAACCGTAGGGGAATC |
| qeCAS9-R2 | GTGTGGGACAAGGGCAGAGA |
| Targeted Gene | Strain/Palsmid | Disruption Efficiency (%) | Transformation Efficiency (CFU/ng) |
|---|---|---|---|
| TRP1 | po1f/pCASyl-trp | 16.61 ± 5.31 | 689.67 ± 62.85 |
| po1f/peCASyl-trp | 35.50 ± 5.22 | 536.67 ± 38.52 | |
| po1fe3-1/pCEN1-Leu-gTrp | 86.09 ± 3.28 | 626.00 ± 57.20 | |
| LIP2 | po1f/pCASyl-trp | 33.61 ± 7.08 | 281.67 ± 57.62 |
| po1f/peCASyl-trp | 62.78 ± 5.20 | 211.33 ± 69.94 | |
| po1fe3-1/pCEN1-Leu-gTrp | 95.19 ± 1.70 | 189.00 ± 50.04 |
Disclaimer/Publisher’s Note: The statements, opinions and data contained in all publications are solely those of the individual author(s) and contributor(s) and not of MDPI and/or the editor(s). MDPI and/or the editor(s) disclaim responsibility for any injury to people or property resulting from any ideas, methods, instructions or products referred to in the content. |
© 2024 by the authors. Licensee MDPI, Basel, Switzerland. This article is an open access article distributed under the terms and conditions of the Creative Commons Attribution (CC BY) license (https://creativecommons.org/licenses/by/4.0/).
Share and Cite
Zhang, B.; Cao, J. Improving and Streamlining Gene Editing in Yarrowia lipolytica via Integration of Engineered Cas9 Protein. J. Fungi 2024, 10, 63. https://doi.org/10.3390/jof10010063
Zhang B, Cao J. Improving and Streamlining Gene Editing in Yarrowia lipolytica via Integration of Engineered Cas9 Protein. Journal of Fungi. 2024; 10(1):63. https://doi.org/10.3390/jof10010063
Chicago/Turabian StyleZhang, Baixi, and Jiacan Cao. 2024. "Improving and Streamlining Gene Editing in Yarrowia lipolytica via Integration of Engineered Cas9 Protein" Journal of Fungi 10, no. 1: 63. https://doi.org/10.3390/jof10010063
APA StyleZhang, B., & Cao, J. (2024). Improving and Streamlining Gene Editing in Yarrowia lipolytica via Integration of Engineered Cas9 Protein. Journal of Fungi, 10(1), 63. https://doi.org/10.3390/jof10010063

